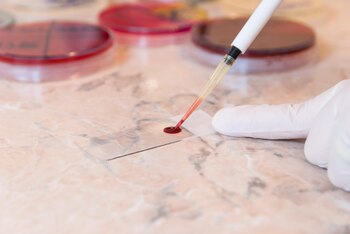

VIERNES, 19 de abril de 2024 (HealthDay News) -- Un marcador temprano de la esclerosis múltiple podría ayudar a los médicos a determinar quién acabará siendo víctima de la enfermedad nerviosa degenerativa, señala un estudio reciente.
En uno de cada 10 casos de EM, el cuerpo comienza a producir un conjunto distintivo de anticuerpos en la sangre años antes de que comiencen a aparecer los síntomas, informaron los investigadores en la edición del 19 de abril de la revista Nature Medicine.
Este patrón de anticuerpos fue 100 por ciento predictivo de un diagnóstico de EM, encontraron los investigadores. Todos los pacientes que portaban este conjunto de anticuerpos desarrollaron EM.
Los investigadores esperan que estos anticuerpos algún día formen la base de un simple análisis de sangre para detectar la EM.
"En las últimas décadas, ha habido un movimiento en el campo para tratar la EM antes y de forma más agresiva con terapias más nuevas y potentes", señaló el investigador sénior, el Dr. Michael Wilson, neurólogo de la Universidad de California, en San Francisco (UCSF).
"Un resultado diagnóstico como este hace que esa intervención temprana sea más probable, lo que da a los pacientes la esperanza de una vida mejor", añadió Wilson en un comunicado de prensa.
La esclerosis múltiple se produce cuando el propio sistema inmunitario del cuerpo ataca al sistema nervioso central, dañando la vaina protectora que rodea las fibras nerviosas llamada mielina. Esto interrumpe las señales hacia y desde el cerebro, causando una variedad de síntomas que impiden los sentidos y afectan la capacidad de moverse.
Se cree que una enfermedad autoinmune como la esclerosis múltiple es el resultado en parte de reacciones inmunitarias raras a infecciones comunes, señalaron los investigadores.
Para este estudio, los investigadores examinaron muestras de sangre tomadas de 250 pacientes con EM recogidas antes y después de su diagnóstico, y las compararon con las muestras de sangre de personas sanas.
Todas las muestras provienen de miembros de las fuerzas armadas de EE. UU., que proporcionan muestras de sangre cuando solicitan unirse a las fuerzas armadas.
Se trataba de "una cohorte fenomenal de individuos a los que observar para ver cómo se desarrolla este tipo de autoinmunidad en el transcurso del inicio clínico de esta enfermedad", señaló el investigador principal, Colin Zamecnik, investigador postdoctoral de la UCSF.
Los investigadores pensaron que verían un aumento en los anticuerpos a medida que los pacientes con EM sufrieran sus primeros síntomas de la enfermedad.
En cambio, encontraron que un 10 por ciento de los pacientes con EM tenían niveles sorprendentemente altos de autoanticuerpos (anticuerpos que pueden atacar al propio cuerpo) años antes de su diagnóstico.
La docena de autoanticuerpos señalados por los investigadores se apegaron a un patrón químico que se asemeja al que se encuentra en los virus comunes. Entre ellos se encuentra el virus de Epstein-Barr, que infecta a más del 85% de todas las personas y ha sido señalado en estudios anteriores como una posible causa contribuyente a la EM.
Esencialmente, este 10 por ciento de los pacientes con EM mostraron señales de una guerra inmunitaria en el cerebro años antes del diagnóstico, dijeron los investigadores. Estos pacientes también tenían niveles elevados de una proteína que se libera a medida que las neuronas se descomponen.
Para confirmar sus hallazgos, los investigadores analizaron muestras de sangre de pacientes en otro estudio que involucraba síntomas neurológicos. Una vez más, el 10% de los pacientes diagnosticados de EM tenían el mismo patrón de autoanticuerpos.
"El diagnóstico no siempre es sencillo para la EM, porque no hemos tenido biomarcadores específicos de la enfermedad", explicó Wilson. "Estamos entusiasmados de tener algo que pueda dar más certeza diagnóstica desde el principio, de tener una discusión concreta sobre si comenzar el tratamiento para cada paciente".
Todavía no está claro qué causa la EM en el otro 90% de los pacientes, pero los investigadores creen que ahora tienen una señal de advertencia temprana definitiva de que la enfermedad se está gestando.
"Imagínese si pudiéramos diagnosticar la EM antes de que algunos pacientes lleguen a la clínica", planteó el investigador sénior, el Dr. Stephen Hauser, director del Instituto Weill de Neurociencias de la UCSF. "Aumenta nuestras posibilidades de pasar de la supresión a la cura".
Más información
La Sociedad Nacional de Esclerosis Múltiple ofrece más información sobre la esclerosis múltiple.
FUENTE: Universidad de California, San Francisco, comunicado de prensa, 19 de abril de 2024
Últimas Noticias
Comenzó la vacunación contra el virus sincicial respiratorio en Argentina: requisitos y a quiénes se aplica
El Ministerio de Salud anunció el inicio de la estrategia de inmunización. Las claves

Músculos y cerebro: por qué la actividad física es clave para la memoria y la salud cognitiva
Las investigaciones muestran que el ejercicio genera señales moleculares que estimulan la formación de nuevas neuronas y ayudan a prevenir el deterioro neurológico

El 99% de los infartos y ACV dan señales de alerta: los cuatro factores de riesgo que se deben vigilar
Un estudio internacional concluyó que identificar y controlar estos indicadores permite anticipar la mayoría de los casos y fortalece las estrategias de prevención

Contaminación en las costas bonaerenses: el 78% de la basura en las playas son plásticos
El último informe realizado por la Red Costera Bonaerense advirtió sobre el preocupante aumento de residuos de ese material, que ahora representa la mayor proporción. Alertan sobre su impacto en la fauna marina

La piel reacciona al calor extremo: cómo prevenir un trastorno frecuente en niños y bebés
La obstrucción de los conductos sudoríparos puede provocar sarpullido, inflamación y picazón, advierten los especialistas


